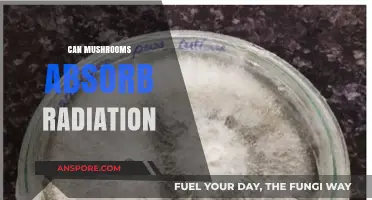
Mushrooms and Radiation: Unveiling Their Surprising Absorption Capabilities

Mushrooms and broccoli are two incredibly versatile and nutritious ingredients that can be combined in a variety of delicious recipes, offering both health benefits and culinary creativity. Rich in vitamins, minerals, and antioxidants, these ingredients complement each other perfectly, whether stir-fried, roasted, or incorporated into soups, salads, or casseroles. From savory mushroom and broccoli stir-fries to creamy pasta dishes and hearty vegetable medleys, the possibilities are endless. Their earthy and slightly nutty flavors blend harmoniously, making them a favorite duo for both vegetarians and meat-eaters alike. Whether you're looking to elevate a weeknight dinner or create a gourmet side dish, exploring recipes that feature mushrooms and broccoli is sure to inspire your cooking and satisfy your taste buds.
| Characteristics | Values |
|---|---|
| Ingredients | Mushrooms, broccoli, olive oil, garlic, salt, pepper, optional: onions, cheese, herbs (e.g., thyme, parsley), cream, soy sauce, lemon juice |
| Cooking Methods | Sautéing, roasting, stir-frying, steaming, grilling, baking |
| Flavor Profiles | Earthy (mushrooms), slightly nutty (broccoli), savory, umami, can be enhanced with garlic, herbs, or cheese |
| Texture | Tender (mushrooms), crisp-tender (broccoli), creamy if added with sauce |
| Health Benefits | Low in calories, high in fiber, vitamins (C, K), minerals (iron, potassium), antioxidants, supports immune health |
| Dietary Suitability | Vegan, vegetarian, gluten-free, keto (if low-carb ingredients are used), paleo |
| Preparation Time | 15-30 minutes (varies by recipe complexity) |
| Serving Suggestions | Side dish, main course (e.g., with rice or pasta), salad topping, stuffed mushrooms with broccoli |
| Popular Variations | Garlic butter mushrooms and broccoli, creamy mushroom and broccoli casserole, Asian-style stir-fry with soy sauce, roasted mushroom and broccoli medley |
| Storage | Best served fresh; leftovers can be stored in the fridge for 2-3 days |
| Pairings | Grilled chicken, steak, tofu, quinoa, mashed potatoes, crusty bread |
| Seasonal Availability | Year-round (mushrooms and broccoli are widely available) |
| Cost | Budget-friendly, affordable ingredients |
| Allergens | None common, but check for added ingredients like nuts or dairy |
Explore related products
What You'll Learn
- Stir-Fry Combinations: Quick, healthy stir-fry recipes blending mushrooms and broccoli with garlic and soy sauce
- Creamy Soups: Velvety mushroom and broccoli soups, enriched with cream or plant-based alternatives for comfort
- Roasted Veggie Medleys: Oven-roasted mushrooms and broccoli seasoned with herbs, olive oil, and a touch of lemon
- Pasta Dishes: Hearty pasta recipes featuring sautéed mushrooms, broccoli florets, and Parmesan cheese for flavor
- Stuffed Mushroom Ideas: Broccoli-stuffed mushrooms baked with cheese, breadcrumbs, and spices for a tasty appetizer

Stir-Fry Combinations: Quick, healthy stir-fry recipes blending mushrooms and broccoli with garlic and soy sauce
Mushrooms and broccoli, when combined in a stir-fry, create a dish that’s both nutrient-dense and satisfyingly flavorful. The earthy umami of mushrooms pairs perfectly with the crisp, slightly sweet broccoli florets, while garlic and soy sauce elevate the entire dish with their aromatic and savory notes. This combination isn’t just a culinary coincidence—it’s a science-backed blend of antioxidants, fiber, and protein, making it an ideal choice for a quick, healthy meal.
To master this stir-fry, start by prepping your ingredients efficiently. Slice 8 ounces of button or cremini mushrooms thinly to maximize surface area for browning, and cut 2 cups of broccoli into bite-sized florets. Mince 3 cloves of garlic for a robust flavor base. Heat 2 tablespoons of avocado or sesame oil in a wok or large skillet over medium-high heat, ensuring the pan is hot enough to sear the vegetables without overcooking them. Add the mushrooms first, stirring occasionally for 3–4 minutes until they release their moisture and begin to brown. This step is crucial for developing their umami richness.
Next, incorporate the broccoli and garlic, stir-frying for another 3–4 minutes until the broccoli turns bright green and slightly tender but still retains its crunch. The garlic should be fragrant but not burnt—keep it moving in the pan to prevent scorching. Drizzle 2–3 tablespoons of low-sodium soy sauce (or tamari for a gluten-free option) over the vegetables, tossing to coat evenly. For added depth, sprinkle in a teaspoon of toasted sesame seeds or a dash of red pepper flakes for heat. Serve immediately over steamed rice or quinoa for a complete meal.
What sets this stir-fry apart is its adaptability. For a protein boost, toss in 1 cup of cooked chicken, tofu, or shrimp during the last 2 minutes of cooking. Vegans can swap soy sauce for coconut aminos and add a splash of lime juice for brightness. Leftovers, if any, reheat well and can be repurposed into wraps or salads. The key is balancing the cooking time to preserve the texture and nutrients of each ingredient, ensuring every bite is as vibrant as the first.
In a world where time is scarce and health is paramount, this mushroom and broccoli stir-fry stands out as a practical, flavorful solution. It’s a testament to how simple ingredients, when combined thoughtfully, can yield a dish that’s both nourishing and satisfying. Whether you’re cooking for one or feeding a family, this recipe proves that quick meals don’t have to compromise on taste or nutrition.
Discover the Best Places to Find Fresh Mushrooms Near You
You may want to see also

Creamy Soups: Velvety mushroom and broccoli soups, enriched with cream or plant-based alternatives for comfort
Mushrooms and broccoli, when blended into creamy soups, create a symphony of flavors and textures that elevate comfort food to a new level. The earthiness of mushrooms pairs seamlessly with the slight nuttiness of broccoli, while the addition of cream or plant-based alternatives transforms the mixture into a velvety, indulgent experience. This combination isn’t just delicious—it’s also nutrient-dense, offering vitamins, fiber, and antioxidants in every spoonful. Whether you’re seeking a cozy weeknight dinner or an elegant starter, this soup delivers both warmth and sophistication.
To craft the perfect creamy mushroom and broccoli soup, start by sautéing aromatic vegetables like onions and garlic in butter or olive oil until translucent. Add sliced mushrooms (shiitake, cremini, or button work well) and cook until they release their moisture and brown slightly, intensifying their umami flavor. Incorporate chopped broccoli florets and stalks, then pour in vegetable or chicken broth and simmer until tender. For a dairy-free version, blend in coconut milk or cashew cream; for a classic approach, stir in heavy cream. Season with salt, pepper, and a pinch of nutmeg for depth. Blend the soup until smooth, then serve with a drizzle of truffle oil or a sprinkle of fresh herbs for an extra layer of luxury.
One of the most appealing aspects of this soup is its versatility. For a heartier meal, add cooked quinoa or shredded chicken. To enhance the creaminess without dairy, soak 1 cup of cashews in hot water for 30 minutes, then blend them into the soup for a rich, silky texture. If you prefer a lighter version, reduce the cream and add more broth, balancing comfort with calorie consciousness. Leftovers can be stored in the fridge for up to 3 days or frozen for later enjoyment, making it an excellent meal-prep option.
Comparing creamy mushroom and broccoli soup to other comfort foods, its health benefits stand out. Unlike heavy mac and cheese or creamy casseroles, this soup provides fiber from broccoli and antioxidants from mushrooms, all while maintaining a satisfying richness. Plant-based alternatives like oat milk or almond cream offer a lighter option without sacrificing flavor, catering to vegan or lactose-intolerant diets. This soup proves that comfort food can be both nourishing and indulgent, making it a standout choice for any table.
Incorporating this soup into your repertoire is simpler than it seems. For busy days, prep ingredients in advance or use pre-chopped vegetables to save time. Garnish with toasted breadcrumbs or a dollop of herb-infused yogurt for added texture and flavor. Pair it with crusty bread or a side salad for a complete meal. Whether you’re cooking for one or feeding a family, creamy mushroom and broccoli soup is a recipe that adapts to your needs, offering comfort in every bowl.
Freezing Fresh Mushrooms: A Guide to Preserving Their Flavor and Texture
You may want to see also

Roasted Veggie Medleys: Oven-roasted mushrooms and broccoli seasoned with herbs, olive oil, and a touch of lemon
Mushrooms and broccoli, when roasted together, create a symphony of flavors and textures that elevate any meal. The earthiness of mushrooms pairs perfectly with the crisp freshness of broccoli, especially when seasoned with herbs, olive oil, and a hint of lemon. This combination not only enhances taste but also maximizes nutritional benefits, as both vegetables are rich in vitamins, fiber, and antioxidants. Roasting them in the oven caramelizes their natural sugars, adding a depth of flavor that steaming or boiling simply can’t achieve.
To prepare this roasted veggie medley, start by preheating your oven to 400°F (200°C). While the oven heats, trim 8 ounces of button or cremini mushrooms and cut them into halves or quarters, depending on size. Toss 3 cups of broccoli florets (fresh or frozen, thawed) with the mushrooms in a large bowl. Drizzle 3 tablespoons of extra virgin olive oil over the vegetables, ensuring even coverage. Add 2 minced garlic cloves, 1 teaspoon of dried thyme (or 1 tablespoon fresh), 1 teaspoon of dried rosemary, a pinch of red pepper flakes (optional for heat), and a generous sprinkle of salt and pepper. Use your hands or a spatula to coat the vegetables thoroughly.
Spread the mixture on a large baking sheet in a single layer to ensure even roasting. Avoid overcrowding, as this can lead to steaming instead of caramelization. Roast for 20–25 minutes, stirring halfway through, until the broccoli is tender and slightly charred at the edges, and the mushrooms are golden brown. In the last 2 minutes, squeeze the juice of half a lemon over the vegetables to brighten the flavors. This step is crucial—the acidity of the lemon cuts through the richness of the olive oil and balances the dish.
What sets this recipe apart is its versatility. Serve it as a side dish alongside grilled chicken or fish, toss it with pasta for a vegetarian main, or fold it into grain bowls with quinoa or farro. For added protein, sprinkle crumbled feta or toasted almonds on top before serving. The key to mastering this medley lies in timing and seasoning—don’t rush the roasting process, and don’t skimp on the herbs. Each ingredient plays a role in creating a dish that’s both comforting and sophisticated.
Finally, consider this recipe a canvas for experimentation. Swap thyme and rosemary for oregano and basil for a Mediterranean twist, or add sliced bell peppers for extra color and sweetness. The beauty of roasted veggie medleys is their adaptability to personal preferences and seasonal ingredients. With minimal effort and maximum flavor, this mushroom and broccoli combination proves that simplicity can be extraordinary.
Can Bleach Kill Mushrooms? A Comprehensive Guide to Fungal Eradication
You may want to see also
Explore related products
$8.58 $19.99

Pasta Dishes: Hearty pasta recipes featuring sautéed mushrooms, broccoli florets, and Parmesan cheese for flavor
Sautéed mushrooms and broccoli florets make an unbeatable duo in pasta dishes, offering both earthy depth and crisp freshness. When combined with the umami richness of Parmesan cheese, this trio transforms simple pasta into a hearty, satisfying meal. The key lies in balancing flavors and textures: the tender bite of mushrooms, the slight crunch of broccoli, and the creamy melt of Parmesan. This combination not only elevates the dish but also ensures a nutrient-packed meal, rich in fiber, vitamins, and antioxidants.
To create a standout pasta dish, start by selecting the right ingredients. Opt for cremini or shiitake mushrooms for their robust flavor, and blanch broccoli florets briefly to retain their vibrant green color and crispness. Cook your pasta al dente—typically 8–10 minutes for penne or fusilli—and reserve a cup of pasta water to adjust consistency later. In a large skillet, sauté the mushrooms in olive oil until golden, then add garlic and red pepper flakes for a subtle kick. Toss in the broccoli and cooked pasta, adding pasta water as needed to create a silky sauce. Finish with a generous sprinkle of freshly grated Parmesan, allowing it to melt slightly and bind the ingredients together.
For a persuasive twist, consider this: a well-executed mushroom, broccoli, and Parmesan pasta is not just a meal—it’s a statement. It proves that plant-based ingredients can rival meat-heavy dishes in flavor and satisfaction. This recipe is versatile, too. Add grilled chicken or shrimp for extra protein, or swap Parmesan for nutritional yeast to make it vegan. Serve it at a dinner party, and watch as guests rave about the harmonious blend of flavors. It’s a dish that feels indulgent yet remains wholesome, making it perfect for any occasion.
Comparatively, this pasta dish outshines others in its simplicity and depth. Unlike cream-based sauces that can feel heavy, the olive oil and Parmesan base here is light yet flavorful. It’s also more forgiving than recipes requiring precise timing, like risotto. While a mushroom risotto demands constant stirring, this pasta allows for multitasking—sauté the vegetables while the pasta boils. The result? A dish that’s just as impressive but far less stressful to prepare.
Finally, a descriptive note: imagine a plate of pasta where each forkful is a symphony of textures and tastes. The mushrooms, caramelized to perfection, release their savory essence, while the broccoli adds a refreshing contrast. The Parmesan, grated just before serving, blankets the dish in salty, nutty richness. It’s comfort food at its finest—warm, inviting, and deeply satisfying. Whether you’re cooking for one or feeding a family, this pasta dish is a testament to the magic that happens when mushrooms, broccoli, and Parmesan come together.
Can You Be Allergic to All Mushrooms? Exploring Fungal Sensitivities
You may want to see also

Stuffed Mushroom Ideas: Broccoli-stuffed mushrooms baked with cheese, breadcrumbs, and spices for a tasty appetizer
Broccoli-stuffed mushrooms are a delightful twist on the classic appetizer, blending the earthy richness of mushrooms with the vibrant freshness of broccoli. This combination not only elevates flavor but also boosts nutritional value, making it a win-win for both taste buds and health-conscious diners. The key to success lies in balancing textures and flavors—crispy breadcrumbs, melted cheese, and aromatic spices complement the tender mushroom caps and slightly crunchy broccoli, creating a harmonious bite.
To prepare this dish, start by preheating your oven to 375°F (190°C). Clean 12 large button or cremini mushrooms by gently wiping them with a damp cloth, then carefully remove the stems. Finely chop the stems and set aside. Steam 1 cup of broccoli florets for 3–4 minutes until just tender, then chop into small pieces. In a skillet, sauté the mushroom stems with 1 minced garlic clove, 2 tablespoons of olive oil, and a pinch of salt and pepper for 5 minutes. Add the broccoli, ¼ cup breadcrumbs, ½ cup shredded cheddar cheese, and 1 teaspoon of Italian seasoning. Stir until combined and slightly toasted.
Stuff each mushroom cap generously with the broccoli mixture, ensuring the filling is compact but not overflowing. Arrange the stuffed mushrooms on a baking sheet lined with parchment paper. Sprinkle the tops with an additional 2 tablespoons of breadcrumbs and ¼ cup of grated Parmesan cheese for a golden, crispy finish. Bake for 15–20 minutes, or until the mushrooms are tender and the topping is browned. For an extra touch, drizzle with a squeeze of lemon juice or a sprinkle of red pepper flakes before serving.
What sets this recipe apart is its versatility. For a lighter version, swap breadcrumbs for almond meal or omit the cheese altogether. Vegans can substitute nutritional yeast for cheese and use plant-based breadcrumbs. Pair these stuffed mushrooms with a tangy dipping sauce like garlic aioli or a balsamic glaze to enhance the flavors further. Whether for a party or a cozy dinner, broccoli-stuffed mushrooms are a crowd-pleaser that proves simplicity and creativity can coexist in the kitchen.
Where to Find Golden Mushroom Soup: A Tasty Treasure Hunt
You may want to see also
Frequently asked questions
Yes, mushrooms and broccoli are a great combination for stir-fries. Both vegetables cook quickly and complement each other in flavor and texture.
Absolutely! Both mushrooms and broccoli are nutrient-dense, offering vitamins, minerals, antioxidants, and fiber. Together, they create a powerhouse of health benefits.
Simple ideas include roasting them with olive oil and garlic, adding them to pasta dishes, or tossing them into omelets or frittatas for a quick and healthy meal.
Yes, they work wonderfully in soups and stews. Their earthy flavors blend well with broths, and they add hearty texture and nutritional value to the dish.